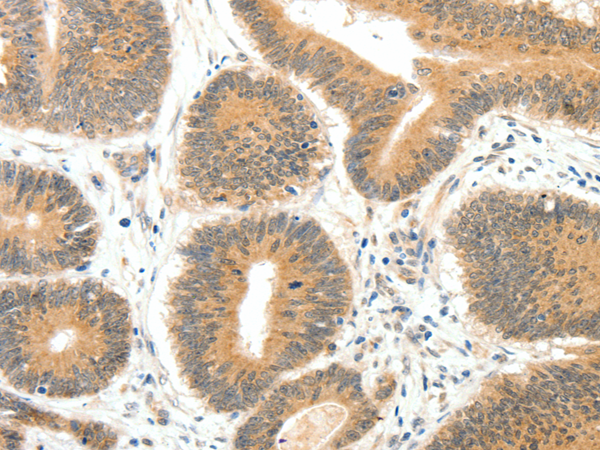
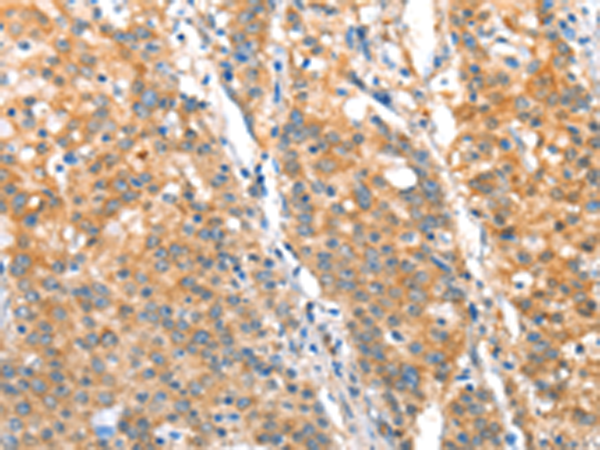

-
分类: 科研抗体货号: P00599别名: PAI; PAI1; PAI-1; PLANH1应用: IHC反应种属: Human, Rat
-
分类: 科研抗体货号: P00527别名: hfzo1, hfzo2应用: IHC反应种属: Human, Mouse, Rat
-
分类: 科研抗体货号: P00454别名: CDF; HGF; HSF; BSF2; IL-6; BSF-2; IFNB2; IFN-beta-2应用: WB,IHC反应种属: Human
-
分类: 科研抗体货号: P00598别名: PAD; PAD4; PDI4; PDI5; PADI5应用: WB,IHC反应种属: Human
-
分类: 科研抗体货号: P00521别名: HAI; MTSP1; SNC19; MT-SP1; PRSS14; TADG15; TMPRSS14应用: IHC反应种属: Human, Mouse
-
分类: 科研抗体货号: P00451别名: IL1; IL-1A; IL1F1; IL1-ALPHA应用: IHC反应种属: Human
-
分类: 科研抗体货号: P00591别名: MEK5, MAPKK5, PRKMK5, HsT17454应用: IHC反应种属: Human, Mouse, Rat
-
分类: 科研抗体货号: P00520别名:应用: WB反应种属: Human, Mouse, Rat
-
分类: 科研抗体货号: P00447别名: KOC; CT98; IMP3; KOC1; IMP-3; VICKZ3应用: WB,IHC反应种属: Human, Mouse
-
分类: 科研抗体货号: P00586别名: OPG, TR1, OCIF应用: WB,IHC反应种属: Human, Mouse, Rat

鄂公网安备42018502007531号
鄂公网安备42018502007531号

